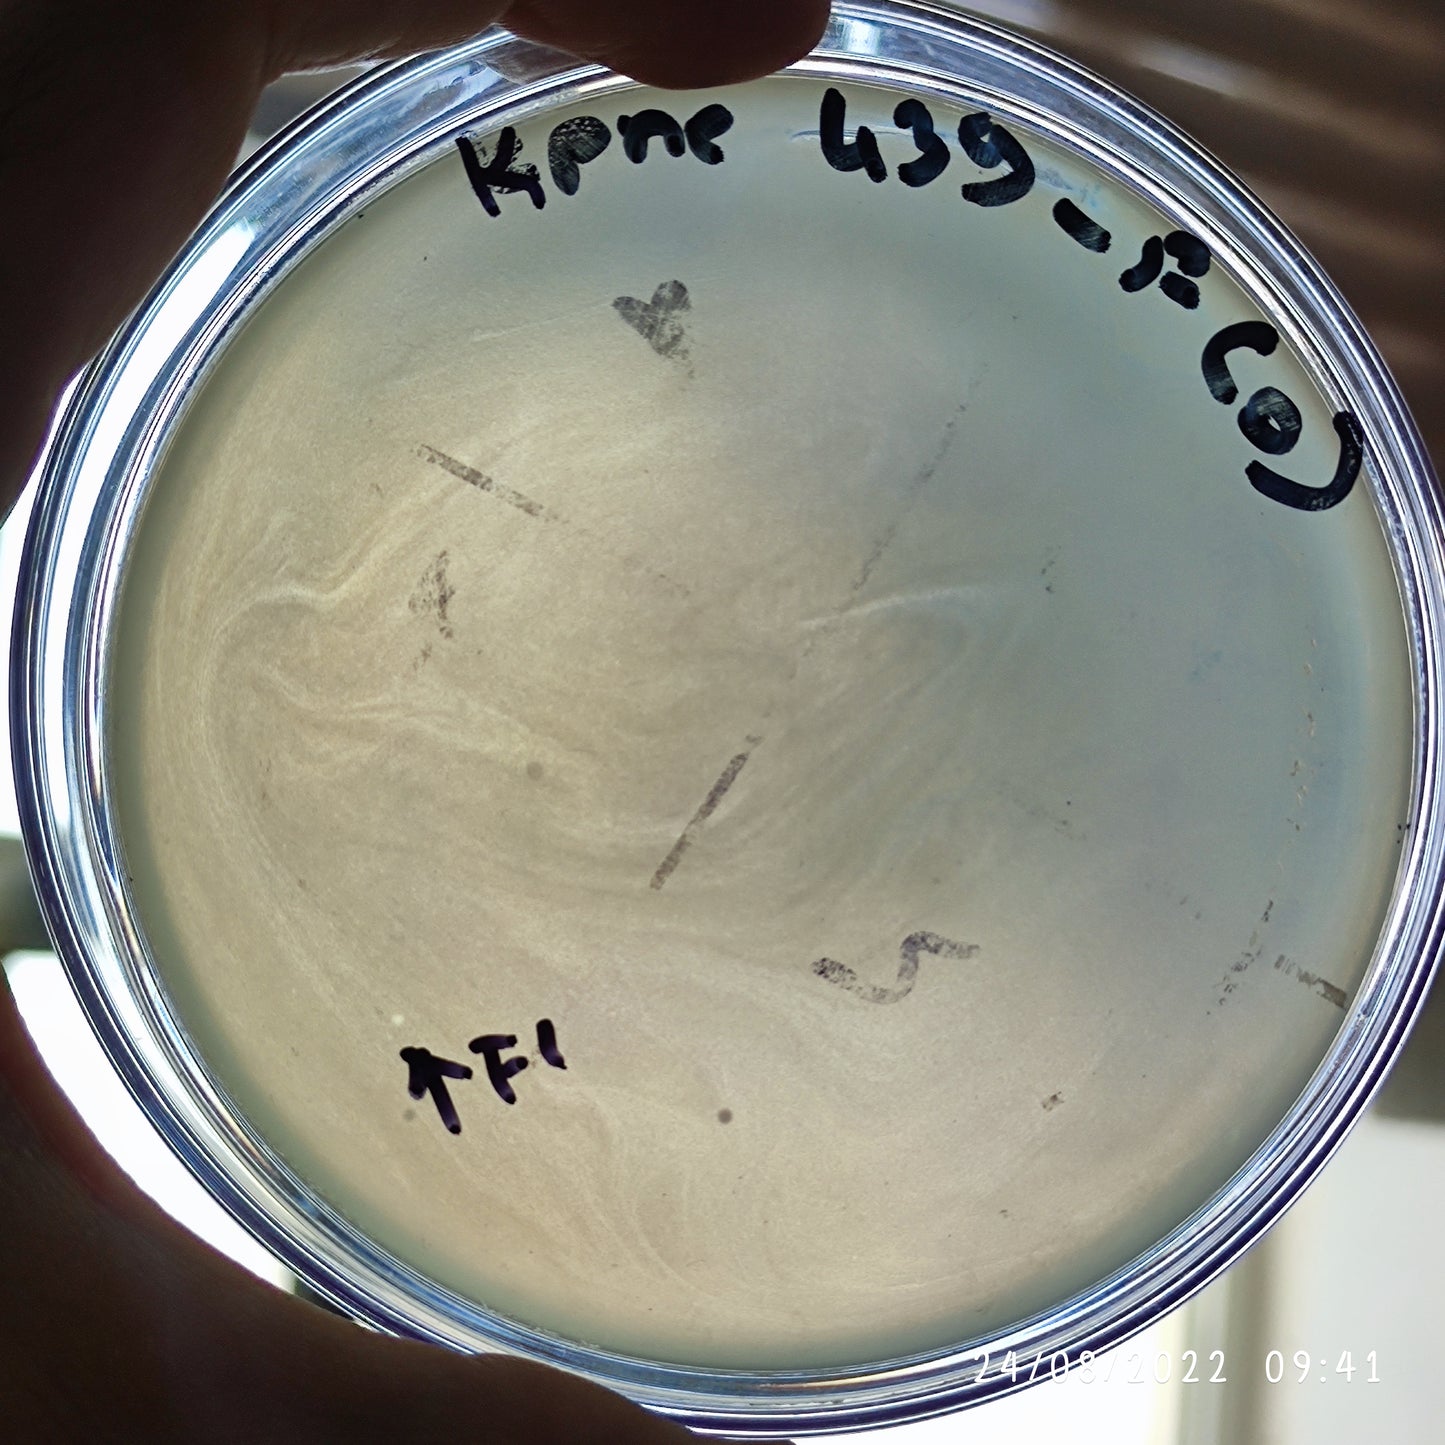

Mikroliz
Klebsiella pneumoniae bacteriophage 180439F
Klebsiella pneumoniae bacteriophage 180439F
Regular price
$750.00 USD
Regular price
Sale price
$750.00 USD
Unit price
per
Tax included.
Couldn't load pickup availability
Product Type
Product Type
Product Format
Product Format
Storage Conditions
Storage Conditions
Bio Safety Level
Bio Safety Level
Cited by
Cited by
Image with text
Pair text with an image to focus on your chosen product, collection, or blog post. Add details on availability, style, or even provide a review.
-
Free Shipping
Pair text with an image to focus on your chosen product, collection, or blog post. Add details on availability, style, or even provide a review.
-
Hassle-Free Exchanges
Pair text with an image to focus on your chosen product, collection, or blog post. Add details on availability, style, or even provide a review.